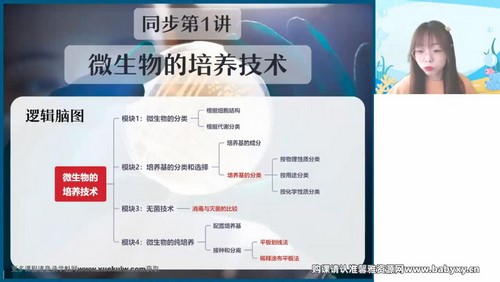
��ҵ��2023ѧ��߶�����лһ������A+�ࣨ10.6G������Ƶ���ٶ����̱���

ҪМУэЕаСө
ЧчТө°п2023С§ДкёЯ¶юЙъОпР»Т»·ІҙәјҫA+°аЈЁ10.6GёЯЗеКУЖөЈ©°Щ¶ИНшЕМұЈҙж
ЈЁЧКФҙұаәЕЈәB9862Ј©ЎЎЎЎЧКФҙДҝВј
ЎЎЎЎ01ЎҫН¬ІҪөЪ1ҪІЎҝОўЙъОпөДЕаСшјјКх.mp4
ЎЎЎЎ02ЎҫН¬ІҪөЪ1ҪІЎҝМвРНҫ«Б·.mp4
ЎЎЎЎ03ЎҫН¬ІҪөЪ2ҪІЎҝОўЙъОпөДСЎФсЕаСшәНјЖКэ.mp4
ЎЎЎЎ04ЎҫКУЖөЎҝМвРНҫ«Б·.mp4
ЎЎЎЎ05ЎҫН¬ІҪөЪ3ҪІЎҝ·ўҪН№ӨіМ.mp4
ЎЎЎЎ06ЎҫН¬ІҪөЪ3ҪІЎҝМвРНҫ«Б·.mp4
ЎЎЎЎ07ЎҫЦұІҘЎҝЦІОпПё°ы№ӨіМ.mp4
ЎЎЎЎ08ЎҫКУЖөЎҝМвРНҫ«Б¶.mp4
ЎЎЎЎ09ЎҫЦұІҘЎҝ¶ҜОпПё°ы№ӨіМ.mp4
ЎЎЎЎ10ЎҫКУЖөЎҝМвРНҫ«Б·.mp4
ЎЎЎЎ11ЎҫЦұІҘЎҝЕЯМҘ№ӨіМ.mp4
ЎЎЎЎ12ЎҫКУЖөЎҝМвРНҫ«Б·.mp4
ЎЎЎЎ13ЎҫЦұІҘЎҝ»щТт№ӨіМөД»щҙЎ.mp4
ЎЎЎЎ14ЎҫКУЖөЎҝМвРНҫ«Б¶.mp4
ЎЎЎЎ15ЎҫЦұІҘЎҝЖЪЦРёҙП°.mp4
ЎЎЎЎ16ЎҫКУЖөЎҝМвРНҫ«Б·.mp4
ЎЎЎЎ17ЎҫН¬ІҪөЪ8ҪІЎҝ»щТт№ӨіМөД»щұҫІЩЧчіМРтәНУҰУГ.mp4
ЎЎЎЎ18ЎҫКУЖөЎҝМвРНҫ«Б·.mp4
ЎЎЎЎ19ЎҫЦұІҘЎҝФӘЛШәНө°°ЧЦК.mp4
ЎЎЎЎ20ЎҫКУЖөЎҝМвРНҫ«Б·.mp4
ЎЎЎЎ21ЎҫЦұІҘЎҝГёөДМШРФәНЗъПЯ·ЦОц.mp4
ЎЎЎЎ22ЎҫКУЖөЎҝМвРНҫ«Б·.mp4
ЎЎЎЎ23ЎҫН¬ІҪөЪ11ҪІЎҝПё°ыөДҪб№№»щҙЎ.mp4
ЎЎЎЎ24ЎҫН¬ІҪөЪ11ҪІЎҝМвРНҫ«Б·.mp4
ЎЎЎЎ25.mp4
ЎЎЎЎ26.mp4
ЎЎЎЎ27ЎҫН¬ІҪөЪ13ҪІЎҝГёөДМШРФәНЗъПЯ·ЦОц.mp4
ЎЎЎЎ28ЎҫН¬ІҪөЪ13ҪІЎҝМвРНҫ«Б· .mp4
ЎЎЎЎ29ЎҫН¬ІҪөЪ14ҪІЎҝПё°ыөДЙъГьАъіМ.mp4
ЎЎЎЎ30ЎҫН¬ІҪөЪ14ҪІЎҝМвРНҫ«Б·.mp4
ЎЎЎЎҝОМГұКјЗ\01ЎҫҝОМГұКјЗЎҝЦчҪІҝОЦРұКјЗ.pdf
ЎЎЎЎҝОМГұКјЗ\02ЎҫҝОМГұКјЗЎҝЦчҪІҝОЦРұКјЗ.pdf
ЎЎЎЎҝОМГұКјЗ\03ЎҫҝОМГұКјЗЎҝЦчҪІҝОЦРұКјЗ.pdf
ЎЎЎЎҝОМГұКјЗ\04ЎҫҝОМГұКјЗЎҝЦчҪІҝОЦРұКјЗ.pdf
ЎЎЎЎҝОМГұКјЗ\05ЎҫҝОМГұКјЗЎҝЦчҪІҝОЦРұКјЗ.pdf
ЎЎЎЎҝОМГұКјЗ\06ЎҫҝОМГұКјЗЎҝЦчҪІҝОЦРұКјЗ.pdf
ЎЎЎЎҝОМГұКјЗ\07ЎҫҝОМГұКјЗЎҝЦчҪІҝОЦРұКјЗ.pdf
ЎЎЎЎҝОМГұКјЗ\09ЎҫҝОМГұКјЗЎҝЦчҪІҝОЦРұКјЗ.pdf
ЎЎЎЎҝОМГұКјЗ\10ЎҫҝОМГұКјЗЎҝЦчҪІҝОЦРұКјЗ.pdf
ЎЎЎЎҝОМГұКјЗ\11ЎҫҝОМГұКјЗЎҝЦчҪІҝОЦРұКјЗ.pdf
ЎЎЎЎҝОМГұКјЗ\12ЎҫҝОМГұКјЗЎҝЦчҪІҝОЦРұКјЗ.pdf
ЎЎЎЎҝОМГұКјЗ\13ЎҫҝОМГұКјЗЎҝЦчҪІҝОЦРұКјЗ.pdf
ЎЎЎЎҝОМГұКјЗ\14ЎҫҝОМГұКјЗЎҝЦчҪІҝОЦРұКјЗ.pdf
ЎЎЎЎҝОМГұКјЗ\15ЎҫҝОМГұКјЗЎҝЦчҪІҝОЦРұКјЗ.pdf
ЎЎЎЎҝОМГұКјЗ\16ЎҫҝОМГұКјЗЎҝЦчҪІҝОЦРұКјЗ.pdf
ЎЎЎЎҝОМГұКјЗ\17ЎҫҝОМГұКјЗЎҝЦчҪІҝОЦРұКјЗ.pdf
ЎЎЎЎҝОМГұКјЗ\18ЎҫҝОМГұКјЗЎҝЦчҪІҝОЦРұКјЗ.pdf
ЎЎЎЎҝОМГұКјЗ\19ЎҫҝОМГұКјЗЎҝЦчҪІҝОЦРұКјЗ.pdf
ЎЎЎЎҝОМГұКјЗ\20ЎҫҝОМГұКјЗЎҝЦчҪІҝОЦРұКјЗ.pdf
ЎЎЎЎҝОМГұКјЗ\21ЎҫҝОМГұКјЗЎҝЦчҪІҝОЦРұКјЗ.pdf
ЎЎЎЎҝОМГұКјЗ\22ЎҫҝОМГұКјЗЎҝЦчҪІҝОЦРұКјЗ.pdf
ЎЎЎЎҝОМГұКјЗ\23ЎҫҝОМГұКјЗЎҝЦчҪІҝОЦРұКјЗ.pdf
ЎЎЎЎҝОМГұКјЗ\24ЎҫҝОМГұКјЗЎҝЦчҪІҝОЦРұКјЗ.pdf
ЎЎЎЎҝОМГұКјЗ\25ЎҫҝОМГұКјЗЎҝЦчҪІҝОЦРұКјЗ.pdf
ЎЎЎЎҝОМГұКјЗ\26ЎҫҝОМГұКјЗЎҝЦчҪІҝОЦРұКјЗ.pdf
ЎЎЎЎҝОМГұКјЗ\27ЎҫҝОМГұКјЗЎҝЦчҪІҝОЦРұКјЗ.pdf
ЎЎЎЎҝОМГұКјЗ\28ЎҫҝОМГұКјЗЎҝЦчҪІҝОЦРұКјЗ.pdf
ЎЎЎЎҝОМГұКјЗ\29ЎҫҝОМГұКјЗЎҝЦчҪІҝОЦРұКјЗ.pdf
ЎЎЎЎҝОМГұКјЗ\30ЎҫҝОМГұКјЗЎҝЦчҪІҝОЦРұКјЗ.pdf
ЎЎЎЎұҫХҫЧКБПҪц№©ХҫіӨұҫИЛІйХТК№УГЈ¬І»¶ФЖдЛыИОәОИЛ·ЦПнЈЎvip»бФұРиТӘЧКБПөДЗл°ҙНшХҫ·ЦПнөДЛСЛчЗюөАЧФРРЛСЛч»сИЎЎЈ
ЎЎЎҫvip»бФұөг»чІйҝҙЛСЛчјјЗЙУлЗюөАЎҝ
ЎЎЧчТө°п2023С§ДкёЯ¶юЙъОпР»Т»·ІҙәјҫA+°аЈЁ10.6GёЯЗеКУЖөЈ©°Щ¶ИНшЕМұЈҙжЈ¬УЙдйцпНшЛСјҜЈ¬Ҫц№©ХҫіӨёцИЛК№УГЈ¬І»¶ФЖдЛыИОәОИЛ·ЦПнЎЈ
ЎЎұҫОДөШЦ·Јәhttp://www.mingkun.top/conn/xsps/9862.html
2026-1-29 3:15:52дҜААБҝЈә2ұкЗ©Јә Р»Т»·І ЙъОп
Па№ШЧКФҙ